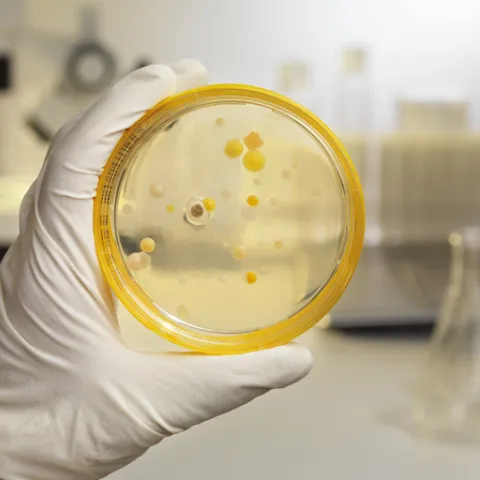
infectious diseases

Accelerating Identification and Treatment of Infectious Diseases Through On-site Next-Generation Sequencing
Mortality rates from treatment-resistant pathogens continue to rise, and the culprits include a wide and growing range of mycobacteria and fungi.
As a former clinically practicing physician who now...